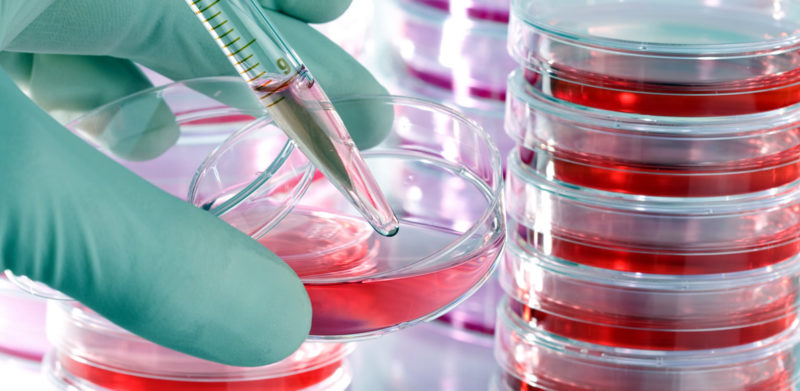

Cura Coreana Anticalvizie: funziona davvero?
La nuova cura coreana anticalvizie farebbe ricrescere davvero i capelli.
Cura Coreana Anticalvizie: dalla sperimentazione di una lozione a base di cellule staminali forse una speranza. Ma cosa c’è di vero?
La Cura Coreana Anticalvizie e le Cellule Staminali: è possibile che una semplice lozione sia in grado di dare scacco alla calvizie? Chiariamo i punti di questa notizia che da circa un mese è possibile leggere sul web e in molte pubblicazioni.
Lozione a base di Staminali?
Cura Coreana Anticalvizie. Cosa si legge sulla cronaca?
La notizia, così come è possibile reperirla sul web o su vari quotidiani cartacei e on-line recita pressapoco così: “Una lozione da applicare sul capo – a base di sostanze prodotte dalle cellule staminali del tessuto adiposo (del grasso corporeo) – fa ricrescere i capelli in caso di una comune forma di calvizie, l’alopecia androgenetica, migliorando densità e spessore dei capelli”.
I risultati di un interessante trial clinico sono stati pubblicati lo scorso 18 maggio (2020 N.d.A.) sulla rivista Stem Cells Translational Medicine. La pubblicazione illustrava le risultanze della ricerca condotta dal gruppo guidato da Sang Yeoup Lee, della Pusan National University Yangsan Hospital in Corea del Sud.
Si è studiato l’effetto dell’applicazione quotidiana di una lozione specifica sul numero e sullo spessore dei capelli di alcuni pazienti afflitti da Alopecia Androgenetica.
“Dobbiamo sempre essere contenti del fatto che la Ricerca Scientifica vada avanti e ci doni nuove strategie possibili di contrasto alla Calvizie…”.
“…la difficoltà maggiore sta però nel trasformare le potenzialità individuate in questi studi in reali terapie di contrasto… e spesso il nodo sta tutto qui”.
Dott. Mauro Conti
Una complessa operazione di estrazione…
Cura Coreana Anticalvizie: complesse le dinamiche di estrazione, coltivazione, tipizzazione e lisi delle staminali…
Ciò che si legge ovunque è la parte legata alle risultanze dell’applicazione della lozione in questione. Su 38 pazienti si è operato un trial che statisticamente ha dato una risposta interessante. Ci son stati infatti segni evidenti di una ripresa di vitalità delle strutture capillari di quei pazienti che hanno provato la lozione per ben sedici settimane.
A maggior riprova di ciò il trial è stato condotto confrontando i risultati di un placebo, dunque nulla da eccepire per quanto riguarda la rilevanza della ricerca. Il problema è semmai nella complessità dei metodi di estrazione di questi principi attivi. Complessità che si ripercuote nei costi elevati di una ipotetica applicazione commerciale.
Senza entrare troppo nello specifico, i principi di rigenerazione cellulare sono prelevati da cellule staminali del tessuto adiposo umano proveniente da donatori sani. Questo substrato viene quindi opportunamente lavorato. Si parla di separazione, messa in coltura, utilizzo di antigeni monoclonali per aumentare la specificità dell’estrazione e altre metodiche che siano in gradi di dare un estratto cellulare molto specifico e dotato di una certa standardizzazione.

…e campione troppo ristretto per essere significativo.
Cura Coreana Anticalvizie: continuare la ricerca su un campione più vasto è il primo passo.
Altro problema da non sottovalutare, ma in un trial non è di per sé un problema, è quello dato dall’esiguità del campione di pazienti su cui è stato condotto lo studio. Si tratta di 38 pazienti dai 18 ai 59 anni di età. Se per una stima preliminare della fondatezza della ricerca questo numero può andare bene, lo stesso non si può dire affiché i risultati dello studio siano univocamente significativi.
È evidente che necessiti un supplemento di indagine su un campione più vasto. Inoltre dobbiamo sperare che il modo di pervenire a questi principi attivi sia decisamente diverso. Donatori volontari di tessuto adiposo significa poca disponibilità di materia prima, che è appunto donata su base volontaria e soprattutto da soggetto che devono essere “supercontrollati” dal punto di vista sanitario. Tutto ciò si traduce, come già anticipato, in costi esorbitanti.
In realtà oggi una via che sfrutta proprio i benefici dei principi di rigenerazione follicolare presenti in ognuno di noi esiste, è collaudati da anni e anni di utilizzo ed è targata “made in Italy”. Stiamo parlando del Protocollo Multidisciplinare di Medicina rigenerativa bSBS.
Il Protocollo bSBS.
Cura Coreana Anticalvizie? Il Protocollo Multidisciplinare bSBS è già qui per noi.
HairClinic BioMedical Group è un’azienda leader nel trattamento dell’Alopecia con metodi innovativi. Il Protocollo di Medicina Rigenerativa bSBS e l’Autotrapianto di Capelli eseguito con tecnica atFUE, sono le nostre due punte di diamante, due vere e proprie eccellenze cliniche che ci forniscono le più elevate possibilità di successo nella lotta alla calvizie.
Nel caso di una calvizie ancora in uno stato incipiente, bSBS agirà come terapia non chirurgica di contrasto.

Se però il rinfoltimento ottenuto non risulta all’altezza delle aspettative, allora si potrà ricorrere ad un autotrapianto di capelli, per dare densità capillare a quelle aree che non abbiamo potuto recuperare in maniera ottimale. I significativi benefici dell’avanzato Protocollo di Medicina Rigenerativa miglioreranno efficacia e durata dell’autotrapianto, favorendo condizioni fisiologiche e di resistenza ai traumatismi della microchirurgia di gran lunga migliori.

“Solo la sinergia tra microchirurgia di rinfoltimento e Protocollo Multidisciplinare sarà in grado di favorire quel potenziamento citato più volte e che darà durata ed efficacia del Trapianto”.
I Vantaggi di bSBS.
I vantaggi del Protocollo Multidisciplinare.
- Consente di affrontare la Caduta di Capelli nella sua totalità.
- Aggredisce la Calvizie su più fronti.
- Non crea traumi, si applica con un micro-ago calibrato.
- Tecnologia più Avanzata al Mondo per la Separazione Cellulare Autologa.
- È una Terapia coordinata sul Paziente e non dissociata e fine sa sé stessa.
- È privo di effetti collaterali e controindicazioni.
- Viene eseguito solo da Medici Specialisti.
- È una pratica Garantita e Sicura.
- È un potenziamento insostituibile del Trapianto di Capelli.
Benefici essenziali, nessuno Escluso.

Parlando di Trapianto di Capelli e necessario supporto e potenziamento, è necessario ribadire che il Protocollo di Medicina Rigenerativa Multidisciplinare incarna tutto questo. Come ormai sappiamo la microchirurgia non basta a guarire la Calvizie perché non è una cura.
In caso di Calvizie avanzata dà senz’altro una mano a coprire i danni e gli inestetismi dati dalla perdita dei Capelli. Però abbiamo necessità che questi risultati estetici siano potenziati e resi stabili nel tempo.
L’azione di bSBS andrà proprio a promuove il riequilibrio degli assetti fisiologici del sistema scalpo-capelli. È questa azione che andrà a favorire quel desiderato potenziamento, presupposto per l’ottenimento di risultati clinicamente validi, naturali e soprattutto di lunga durata.
Recensioni.
Recensioni Certificate sul Protocollo Rigenerativo.

Recensioni Protocollo di Medicina Rigenerativa bSBS. Oltre 1400 Recensioni Certificate e decine di Video Testimonianze e Valutazioni di veri Pazienti. Ogni Recensione è Certificata da Feedaty. HairClinic raccoglie le recensioni in forma cartacea e controfirmata dal paziente e le consegna a Feedaty la quale pubblica le sole valutazioni. Guarda altre video Recensioni: HairClinic Recensioni Certificate.
HairClinic Academy.
Ogni giorno noi vogliamo comprendere perché alcune terapie non portano a risultati duraturi. Perché un Trapianto di Capelli non basta a risolvere la calvizie? Quali azioni si possono intraprendere per agire in modo serio e completo? Vogliamo scoprire quale sia l’approccio terapeutico più avanzato per affrontare anche la tua calvizie. Questo e molto altro viene spiegato dal Dott. Mauro Conti nei Video Academy, guardali adesso.
Premio Le Fonti INNOVATION Awards®.

HairClinc Academy è Eccellenza nella Cura della Calvizie. Guarda la news completa.
Interviste e Media.
AdnKronos, Agi Stampa, Ansa, TgCom24, Tg StudioAperto Italia1, TG5 Salute e Molti altri.
- TgCom24.it Canale Salute di Mediaset.
- Cura Coreana anticalvizie, il Trapianto di Capelli su Wikipedia.
- Cura Coreana anticalvizie, l’Alopecia Androgenetica su Wikipedia
- Pubblicazioni Scientifiche su Nature.com.
- Pubblicazioni su hCRP Angel su NCBI Magazine.
- Lo studio pubblicato su Stem Cells Translational Medicine (inglese).
Leggi di più.
- Il PRP per Capelli non basta, serve un Protocollo Multidisciplinare.
- PRF Capelli, la non novità.
- IDI di Roma e PRF.
bSBS – FAQ.
Le domande più frequenti sul Protocollo bSBS.
L’Alopecia Androgenetica (AGA) è il vero nome della cosiddetta Calvizie Comune Ereditaria. Diffusissima in tutto il mondo consiste in un progressivo rimpicciolimento dei capelli. Ciclo vitale dopo ciclo vitale, questi cadono per ricrescere sempre più deboli e sfibrati fino all’atrofia del Capello. Anche se gli uomini sono i soggetti che ne soffrono con più frequenza, anche le donne ne sono affette in modo sempre più evidente.
Sono due semplicissime molecole naturali: il Diidrotestosterone (DHT) e la Prostaglandina D2 (PGD2). Il primo è la forma ridotta del Testosterone. Per azione di un enzima, la 5-alfa-Reduttasi il Testosterone si trasforma in DHT che è responsabile dello squilibrio del Cuoio Capelluto e dei Bulbi Capillari. La PGD2 invece sostiene una condizione infiammatoria cronica che aggrava i danni dati dal DHT.
La calvizie non ha distinzione di genere. Si tratta della stessa condizione di Caduta dei Capelli. Effettivamente la sintomatologia ha delle differenze, ma DHT e PGD2 sono i responsabili comuni. A loro si deve la sofferenza dei capelli che nella donna porta ad un indebolimento prevalente sulla parte superiore del capo. Nell’uomo invece è comune la nota perdita di capelli sulle tempie e sul vertex. Queste quindi procedono per lasciare infine la classica “coroncina” di capelli in zona parietale ed occipitale del capo.
Lo stress e altri fattori esterni possono certamente concorrere al peggioramento di una forma di Calvizie. In questo caso più che di cause parleremo di concause esterne alla Caduta di Capelli. Un esempio possono essere cattive abitudini alimentari, eccessi e abusi o altre patologie.
La risposta è decisamente no! O almeno non se si tratta di lozioni cosmetiche. Una lozione, uno shampoo, una maschera rigenerante per capelli non possono nulla sulle vere cause della Caduta dei Capelli. Queste infatti si nascondono ben al di sotto della cute dove tali cosmetici agiscono.
Che combattano la calvizie no, ma una corretta integrazione può metterci in una situazione decisamente migliore . È vero infatti che condizioni di malnutrizione o semplici carenze alimentari possano avere un effetto negativo sulla salute generale di capelli e cuoio capelluto. È però anche vero che non esiste un integratore che da solo sia in grado di curare la calvizie.
La risposta qui è… no, ma parliamone. Il PRP Capelli è stata la prima terapia per la stimolazione cellulare dei Capelli con qualche difficoltà. Le sue basi sono ben salde nel campo della Medicina Rigenerativa. Il gel piastrinico che contiene tutti i principi di Rigenerazione Cellulare è effettivamente in grado di agire sul Capello. Però da solo non basta. Il PRP Capelli non può essere definita come una vera cura della Calvizie per molti motivi. Senza dubbio però, il più importante è che esso viene usato come una terapia isolata e fine a sé stessa.
No, il Trapianto di Capelli non basta. Esso copre i danni dati dalla Calvizie. Questo è infatti il motivo per il quale è indicato nelle calvizie molto estese, ma decisamente non è una cura. DHT e PGD2 continueranno nella loro attività distruttiva, tanto che un Trapianto non potenziato non può durare a lungo. Dopo due o tre anni è da ripetere. È qui che la Medicina Rigenerativa si inserisce e potenzia i risultati del Trapianto di Capelli rendendoli più naturali, duraturi ed efficaci.
Il Trapianto di Capelli è uno strumento utile quando la Calvizie sia andata un po’ troppo avanti. Sappiamo infatti che in casi di evoluzione un po’ troppo spinta i Follicoli Capillari si atrofizzano. Questa è una situazione di non ritorno che lascia zone glabre o diradate. Il Trapianto in questo caso agisce sul rinfoltimento chirurgico di queste aree, di fatto coprendo i danni estetici. Ma ribadiamo il concetto che un Trapianto non potenziato sarà da rifare nel giro di due o tre anni.
Sì, ma in HairClinic non si fa semplicemente un Trapianto di Capelli, si fa Advanced MicroSurgery. Questa è un’associazione tra Protocollo bSBS e l’avanzata tecnologia di Trapianto Monobulbare atFUE. Si tratta di un Trapianto avanzatissimo che gode del potenziamento dato dal Protocollo Multidisciplinare più all’avanguardia oggi sulla scena. Una vera e propria accoppiata vincente per garantire le migliori possibilità di successo contro la calvizie, anche quella un po’ più avanzata.
Il Protocollo Multidisciplinare di Medicina Rigenerativa bSBS è un insieme di avanzate applicazioni cliniche. Queste insieme agiscono per favorire un efficace contrasto alla Caduta di Capelli. Non si tratta dunque della cura di un solo aspetto, ma un attacco a 360 gradi a tutte le componenti di uno squilibrio complesso come la Calvizie.
Il Protocollo di Medicina Rigenerativa Multidisciplinare bSBS, ha un costo di 3600,00 Euro. Viene eseguito una volta sola e tutte le tecnologie che lo compongono agiscono, ognuna su un aspetto differente della calvizie. Può prevedere 1 o 2 richiami nel primo anno, oppure dal secondo al quinto anno. I Richiami sono inclusi nei costi.
No. I principi di Rigenerazione Cellulare alla base della sua azione sono autologhi. Questo è il motivo per il quale sono ben tollerati dal paziente. Essi sono in un primo momento prelevati e poi reintrodotti nella cute del paziente in un secondo.
Trovate più informazioni sul bSBS cliccando qui.